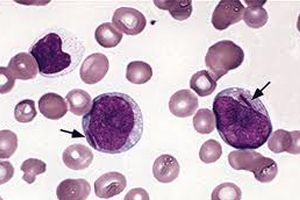

Η σχέση του γονιδίου με τον καρκίνο του αίματος ανακαλύφθηκε και παρουσιάστηκε σε Πανευρωπαϊκό Συνέδριο της Στοκχόλμης, σε ένα φόρουμ για συνεργασίες ανάμεσα στους κορυφαίους του καρκίνου και στη γονιδιακή έρευνα. Τη σημαντική αυτή ανακάλυψη έκαναν ερευνητές του Sanger Institute, του Τμήματος Αιματολογίας του Πανεπιστημίου του Cambridge και του Τμήματος Αιματολογίας του Νοσοκομείου Addenbrooke, και πίσω από αυτή βρίσκεται μια Ελληνίδα γενετίστρια- βιολόγος, η Δρ. Έλλη Παπαεμμανουήλ, που ως επικεφαλής ερευνητικής ομάδας είχε ανακαλύψει το γονίδιο που προκαλεί την παιδική λευχαιμία. Το συμπέρασμα της έρευνας για τη μυελοδυσπλασία είναι ότι νέες γενετικές ενδοσκοπήσεις θα διευκόλυναν τον προσυμπτωματικό έλεγχο μετάλλαξης.

Ως γνωστόν, οι Έλληνες επιστήμονες μεγαλουργούν, αλλά συνήθως μόνο στο εξωτερικό. Η zougla.gr επικοινώνησε με την Έλλη Παπαεμμανουήλ προκειμένου να διαπιστώσει σε τι μπορούν να ελπίζουν πλέον εκατομμύρια ασθενείς σε όλο τον κόσμο.
Zougla.gr: Δόκτωρ Παπαεμμανουήλ, μιλήστε μας για την ανακάλυψη σας. Σε τι μπορούν να ελπίζουν οι ασθενείς και πώς προωθεί την επιστήμη;
Έλλη Παπαεμμανουήλ: Τα μυελοδυσπλαστικά σύνδρομα (ΜΔΣ) είναι χρόνια μυελοειδή νεοπλάσματα, τα οποία προσβάλλουν 1 άτομο ανά 25.000. Καθώς το 80% των πασχόντων από ΜΔΣ είναι μεγαλύτεροι των 60 ετών και δεδομένης της γήρανσης του πληθυσμού, τα ΜΔΣ αναδεικνύονται πλέον στην ποιο συχνή μορφή μυελοειδούς καρκίνου.
Οι ασθενείς με ΜΔΣ εμφανίζονται στο νοσοκομείο με σοβαρή αναιμία, μώλωπες, αιμορραγία και συχνές μολύνσεις. Αυτό αποδίδεται στο γεγονός, ότι ο νωτιαίος μυελός τους αδυνατεί να παράξει σωστά ερυθρά αιμοσφαίρια, αιμοπετάλια και λευκοκύτταρα. Προκειμένου ο ιατρός να μπορέσει να διαγνώσει ΜΔΣ, ο ασθενής θα πρέπει να υποβληθεί σε σειρά αιματολογικών εξετάσεων καιτελικά σε βιοψία νωτιαίου μυελού, μια διαδικασία επώδυνη και χρονοβόρα. Σε αρκετές περιπτώσεις ασθενείς περιμένουν έως και δύο χρόνια μέχρι να ληφθεί σωστή διάγνωση, διάστημα κατά το οποίο θα μπορούσε η νόσος να μετεξελιχθεί σε οξεία μυελοειδή λευχαιμία, με πολύ δυσάρεστα αποτελέσματα. Επίσης, uπολογίζεται, ότι για ένα πολύ μεγάλο ποσοστό πασχόντων από ΜΔΣ δεν διαγνώζονται ποτέ, με αποτέλεσμα αυτοί να μην υποβάλλονται ποτέ στη σωστή θεραπεία και φαρμακευτική αγωγή.
Με στόχο να ανακαλύψουμε τα αιτία που οδηγούν στην δημιουργία της μυελοδυσπλασίας σε μοριακό επίπεδο, χρησιμοποιώντας τεχνολογία αποκωδικοποίησης DNA νέας γενιάς, αναλύσαμε τα γονιδιώματα εννέα ασθενών, που έπασχαν από ΜΔΣ. Αναλύσαμε περισσότερα από 22.000 γονίδια ανά ασθενή και, προς μεγάλη μας έκπληξη, διαπιστώσαμε, ότι το ίδιο γονίδιο, το SF3B1, είχε υποστεί μεταλλάξεις σε 6 από τους 9 ασθενείς. Το SF3B1 κωδικοποιεί ένα συστατικό του πυρήνα splicing του RNA, έναν σημαντικό μηχανισμό επεξεργασίας, που ελέγχει το πώς μεταφέρεται στο κύτταρο το μήνυμα του γονιδιώματος.
Προκειμένου να καταλάβουμε την συχνότητα με την οποία εμφανίζονται μεταλάξεις στο γονίδιο SF3B1, αναλύσαμε περισσότερα από 1.000 μυελοειδή νεοπλάσματα και, επίσης, περισσότερα από 1.000 δείγματα καρκίνου. Διαπιστώσαμε, ότι το γονίδιο SF3B1 ήταν αυτό που μεταλλάσσεται στις περισσότερες περιπτώσεις ΜΔΣ και το οποίο σχετίζεται με έναν συγκεκριμένο τύπο ΜΔΣ, την ανθεκτική αναιμία με σιδηροβλάστες δακτυλίου. Συγκριτική μελέτη ασθενών με και χωρίς τη μετάλλαξη έδειξε, ότι όσοι από αυτούς εμφανίζουν τη μετάλλαξη του γονιδίου SF3B1, ζουν περισσότερο και εμφανίζουν μειωμένο κίνδυνο μετεξέλιξης της νόσου σε οξεία μυελοειδή λευχαιμία.
 Τα αποτελέσματα των ερευνών μας δείχνουν πλέον σαφώς, ότι είναι δυνατόν να έχουμε ένα στοχευόμενο διαγνωστικό τεστ, το οποίο να εντοπίζει τις μεταλλάξεις μέσω αιματολογικών εξετάσεων, συντελώντας, καταυτόν τον τρόπο, στην ταχύτερη επίτευξη ακριβούς διάγνωσης της ασθενείας, χωρίς να χρειάζεται να καταφύγουμε σε βιοψία νωτιαίου μυελού. Αυτό το τεστ θα μπορούσε να ξεκινήσει να γίνεται ακόμη και μέσα στον επόμενο χρόνο, στα νοσοκομεία. Εξίσου σημαντικό είναι και το να γνωρίζουμε τον βαθμό στον οποίο λαμβάνουν χώρα οι μεταλλάξεις αυτές στον κάθε ασθενή, δεδομένου ότι κάτι τέτοιο θα δρούσε ενημερωτικά για τον ιατρό αιματολόγο, όσον αφορά τους κινδύνους που διατρέχει ο συγκεκριμένος ασθενής, οπότε θα οδηγούσε στη λήψη των καλύτερων δυνατών αποφάσεων. Προσδοκούμε ότι η ανακάλυψη του SF3B1 θα μπορέσει να βοηθήσει την ιατρική παρακολούθηση του ασθενούς από τη διάγνωση έως και την επιλογή σωστής θεραπείας.
Τα αποτελέσματα των ερευνών μας δείχνουν πλέον σαφώς, ότι είναι δυνατόν να έχουμε ένα στοχευόμενο διαγνωστικό τεστ, το οποίο να εντοπίζει τις μεταλλάξεις μέσω αιματολογικών εξετάσεων, συντελώντας, καταυτόν τον τρόπο, στην ταχύτερη επίτευξη ακριβούς διάγνωσης της ασθενείας, χωρίς να χρειάζεται να καταφύγουμε σε βιοψία νωτιαίου μυελού. Αυτό το τεστ θα μπορούσε να ξεκινήσει να γίνεται ακόμη και μέσα στον επόμενο χρόνο, στα νοσοκομεία. Εξίσου σημαντικό είναι και το να γνωρίζουμε τον βαθμό στον οποίο λαμβάνουν χώρα οι μεταλλάξεις αυτές στον κάθε ασθενή, δεδομένου ότι κάτι τέτοιο θα δρούσε ενημερωτικά για τον ιατρό αιματολόγο, όσον αφορά τους κινδύνους που διατρέχει ο συγκεκριμένος ασθενής, οπότε θα οδηγούσε στη λήψη των καλύτερων δυνατών αποφάσεων. Προσδοκούμε ότι η ανακάλυψη του SF3B1 θα μπορέσει να βοηθήσει την ιατρική παρακολούθηση του ασθενούς από τη διάγνωση έως και την επιλογή σωστής θεραπείας.
Ανακαλύψαμε, επιπροσθέτως, ότι το SF3B1 είναι το γονίδιο, που μεταλλάσσεται συχνά, σε ποσοστό 2-5%, στις πλέον κοινές μορφές καρκίνου, όπως μαστών, νεφρών, μυέλωμα κ.ο.κ. Το γεγονός αυτό ανάγει την ταυτοποίηση του SF3B1 σε σημαντικότατο βήμα προς την κατανόηση της απορρέουσας μοριακής παθολογίας της μυελοειδούς λευχαιμίας, αλλά και άλλων κοινών μορφών καρκίνου. Επίσης, o εντοπισμός των μεταλλάξεων του γονιδίου SF3B1, στην περίπτωση του ΜΔΣ και άλλων κοινών μορφών καρκίνου θέτει γερές βάσεις για πιθανή έρευνα στο χώρο της θεραπευτικής αγωγής κατά του καρκίνου.
Πείτε μας λίγα λόγια για τον εαυτό σας. Πού μεγαλώσατε, πού σπουδάσατε, σε τι ακριβώς αφορούν οι έρευνες σας;
Γεννημένη στην Αθήνα και έχοντας επιπλέον ζήσει στο Λονδίνο και τη Νάπολη της Ιταλίας, αποφάσισα να ακολουθήσω ακαδημαϊκή πορεία στο χώρο της μοριακής γενετικής, οπότε και επέστρεψα στο Ηνωμένο Βασίλειο, με σκοπό να σπουδάσω στο Πανεπιστήμιο της Γλασκώβης. Δείχνοντας ιδιαίτερο ενδιαφέρον για την έρευνα και επιζητώντας μία καριέρα πάνω στην έρευνα για τον καρκίνο, πήρα υποτροφία για διδακτορικό για το Ίδρυμα Έρευνας κατά του Καρκίνου, στο Λονδίνο. Εκεί, διεξήγαγα έρευνες σχετικές με τη γενετική προδιάθεση για καρκίνο του παχέος εντέρου και για παιδική λευχαιμία όπου και δημοσίευσα σχετικά με την ταυτοποίηση του πρώτου γονιδιακού locus, που σχετίζεται με τον αυξημένο κίνδυνο εμφάνισης παιδικής λευχαιμίας. Στη συνέχεια, μετακόμισα στο Cambridge, προκειμένου να εργαστώ στο «Wellcome Trust Sanger Genome Campus», ένα από τα κορυφαία κέντρα γονιδιακής έρευνας στον κόσμο.

Εδώ έχω την ευκαιρία να συνεργάζομαι με πολύ ιδιαίτερους ερευνητές που σέβομαι παρά πολύ και να συνεχίσω την έρευνα μου στο χώρο της παιδικής λευχαιμίας, όπως και την αναζήτηση των γενικότερων αιτίων που οδηγούν σε μυελοειδή λευχαιμία. Παράλληλα, διδάσκω στους τελειόφοιτους της μοριακής γενετικής στο Πανεπιστήμιο της Γλασκώβης μία φορά το χρόνο, κάτι που με ευχαριστεί παρά πολύ καθώς πριν από 7 χρόνια ήμουν εγώ μια από αυτούς! Γενικώς ταξιδεύω αρκετά λόγω δουλειάς και συνεδρίων μου αρέσει επίσης να ανακαλύπτω καινούργια μέρη, να μαθαίνω νέες κουλτούρες και πάνω από όλα να δοκιμάζω νέες γεύσεις! Δυστυχώς αυτό το κάνω λιγότερο από ότι παλαιότερα, αλλά οπότε μπορώ προσπαθώ να συνδυάσω τα ταξίδια με τον εθελοντισμό, ενώ παράλληλα προσπαθώ να μάθω surfing – για αυτό θα χρειαστώ λίγο ακόμα χρόνο!
Πόσο δύσκολο είναι για μία Ελληνίδα επιστήμονα να παράγει έργο στην πατρίδα της; Γιατί οι περισσότεροι Έλληνες καταφεύγουν στο εξωτερικό;
Η έρευνα πάνω στη γενετική είναι ιδιαίτερα δαπανηρή και τα ελληνικά ερευνητικά ιδρύματα και πανεπιστήμια δεν διαθέτουν τα απαιτούμενα κονδύλια για να υποστηρίξουν κάτι τέτοιο. Στη Βρετανία, αλλά και σε άλλες χώρες, η χρηματοδότηση της έρευνας είναι σημαντικότατη και οι δυνατότητες υποστήριξης μεγάλες. Εντούτοις, δεν είναι μόνο το θέμα της χρηματοδότησης αυτό που μετράει, εφόσον οι δυνατότητες αυτές, σε συνδυασμό με σκληρή δουλειά σε ένα περιβάλλον αξιοκρατικό, που προωθεί τη συμμετοχή στη γνώση και την προσωπική ανέλιξη σε όλες τις βαθμίδες εργασίας, παίζουν πρωτεύοντα ρόλο.
 Στην Ελλάδα μπορεί τα κονδύλια για την έρευνα να είναι πολύ περιορισμένα -τουλάχιστον προς το παρόν- πλην όμως, εάν δουλέψουμε σκληρά και θέσουμε στόχους, εναπόκειται σε μας πλέον το κατά πόσον θα επιλέξουμε να δημιουργήσουμε ευκαιρίες στο μέλλον. Κάτι άλλο βασικό είναι το ότι, εάν δεν μπορούμε να διεξάγουμε οι ίδιοι έρευνες, μπορούμε εντούτοις να παραμένουμε ενημερωμένοι για τις τελευταίες εξελίξεις. Οι Έλληνες ιατροί και ερευνητές έχουν την ευκαιρία να επισκέπτονται σημαντικότατα συνέδρια ανά την υφήλιο, επομένως είναι επιλογή τους το αν θα επιλέξουν να εμπλακούν, στα πλαίσια τέτοιων συνεδρίων, ενεργά και αν θα συνεργασθούν δυναμικά με αλλά ερευνητικά κέντρα, διεθνώς. Έτσι θα μπορούν να ενημερώνονται κάθε φορά σχετικά με τα τελευταία επιτεύγματα, γεγονός που θα έχει απήχηση στη νοσοκομειακή εικόνα τους και στους ασθενείς τους. Επομένως, εγώ προσωπικά θα ενθάρρυνα τους Έλληνες ερευνητές να συμμετέχουν σε τέτοιες προσπάθειες.
Στην Ελλάδα μπορεί τα κονδύλια για την έρευνα να είναι πολύ περιορισμένα -τουλάχιστον προς το παρόν- πλην όμως, εάν δουλέψουμε σκληρά και θέσουμε στόχους, εναπόκειται σε μας πλέον το κατά πόσον θα επιλέξουμε να δημιουργήσουμε ευκαιρίες στο μέλλον. Κάτι άλλο βασικό είναι το ότι, εάν δεν μπορούμε να διεξάγουμε οι ίδιοι έρευνες, μπορούμε εντούτοις να παραμένουμε ενημερωμένοι για τις τελευταίες εξελίξεις. Οι Έλληνες ιατροί και ερευνητές έχουν την ευκαιρία να επισκέπτονται σημαντικότατα συνέδρια ανά την υφήλιο, επομένως είναι επιλογή τους το αν θα επιλέξουν να εμπλακούν, στα πλαίσια τέτοιων συνεδρίων, ενεργά και αν θα συνεργασθούν δυναμικά με αλλά ερευνητικά κέντρα, διεθνώς. Έτσι θα μπορούν να ενημερώνονται κάθε φορά σχετικά με τα τελευταία επιτεύγματα, γεγονός που θα έχει απήχηση στη νοσοκομειακή εικόνα τους και στους ασθενείς τους. Επομένως, εγώ προσωπικά θα ενθάρρυνα τους Έλληνες ερευνητές να συμμετέχουν σε τέτοιες προσπάθειες.
Συνέντευξη: Σωτήρης Σκουλούδης










